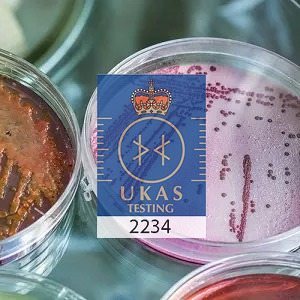

Description
TVC Water Testing
- Royal Mail Special Delivery return packet to make the results UKAS approved. (To drop off at Post Office)
- Insulated/pre-paid return packaging
- Expert interpretation and advice available
- Immediate reporting of any positive results
- Confidential service
TVC sample kit with water analysis performed by our in-house UKAS accredited laboratory.
TVC or Total Viable Count can also be expressed as Aerobic Colony Count.
TVC/Areobic Colony Count is a basic measure of bacterial activity in a water sample. No limits are set for this in the UK but it is possible to interpret the result to indicate potential poor water hygiene issues. Testing TVC levels regularly to monitor for any upward change can be useful to identify any developing issues within the water system.
It has never been easier – simply click and pay and we will send you a TVC sampling pack and instructions. You collect the sample and post it back to us in the pre-paid package provided. We will start the TVC water testing immediately and send you the results as soon as they are available.
Unlike other labs which simply give you results, Feedwater, specialise in solving water related problems so we can explain what the results mean and can provide a full range of services to help you resolve your problem.
We include a pre-paid Special Delivery mail bag with your packet, you must be able to get to a post office same day as sampling. If you know this isn’t possible speak to us about our courier collection option (this is at extra charge).
Taking your Sample
To ensure the sample meets UKAS accreditation we must stress the customer take these steps in its return:
- Freeze gel packs over night and place in insulated box.
- Sample in the morning and take the packet to the Post Office before last collection.
This product requires insulated packaging to prevent the bacterial levels from changing in the post, the insulated packaging is therefore mandatory.
If you bulk order and will be sending samples back individually or in other amounts you will need us to send you individual insulated packages to return the samples. We have insulated packs of differing sizes so you can allocate as many samples as you wish to a single pack all for one price.
It is preferable the sample be taken and posted the same day to arrive within 24 hours to ensure accurate analysis. Samples can be taken Monday to Thursday but not Friday as the lab is not open weekends.
Results are ready between 2 – 3 days depending on the nature of the sample either domestic or industrial.

Philip Horsfield (verified owner) –
We used the TVC testing service for legionella. It couldn’t have been simpler, and came with very easy to follow instructions. We will definitely be using this service as our on-going test supplier
Philip Horsfield (verified owner) –
We use the postal TVC testing service for Legionella, and it is simple & efficient, with the results emailed back to us. It is an ideal system for us. Very happy with service.